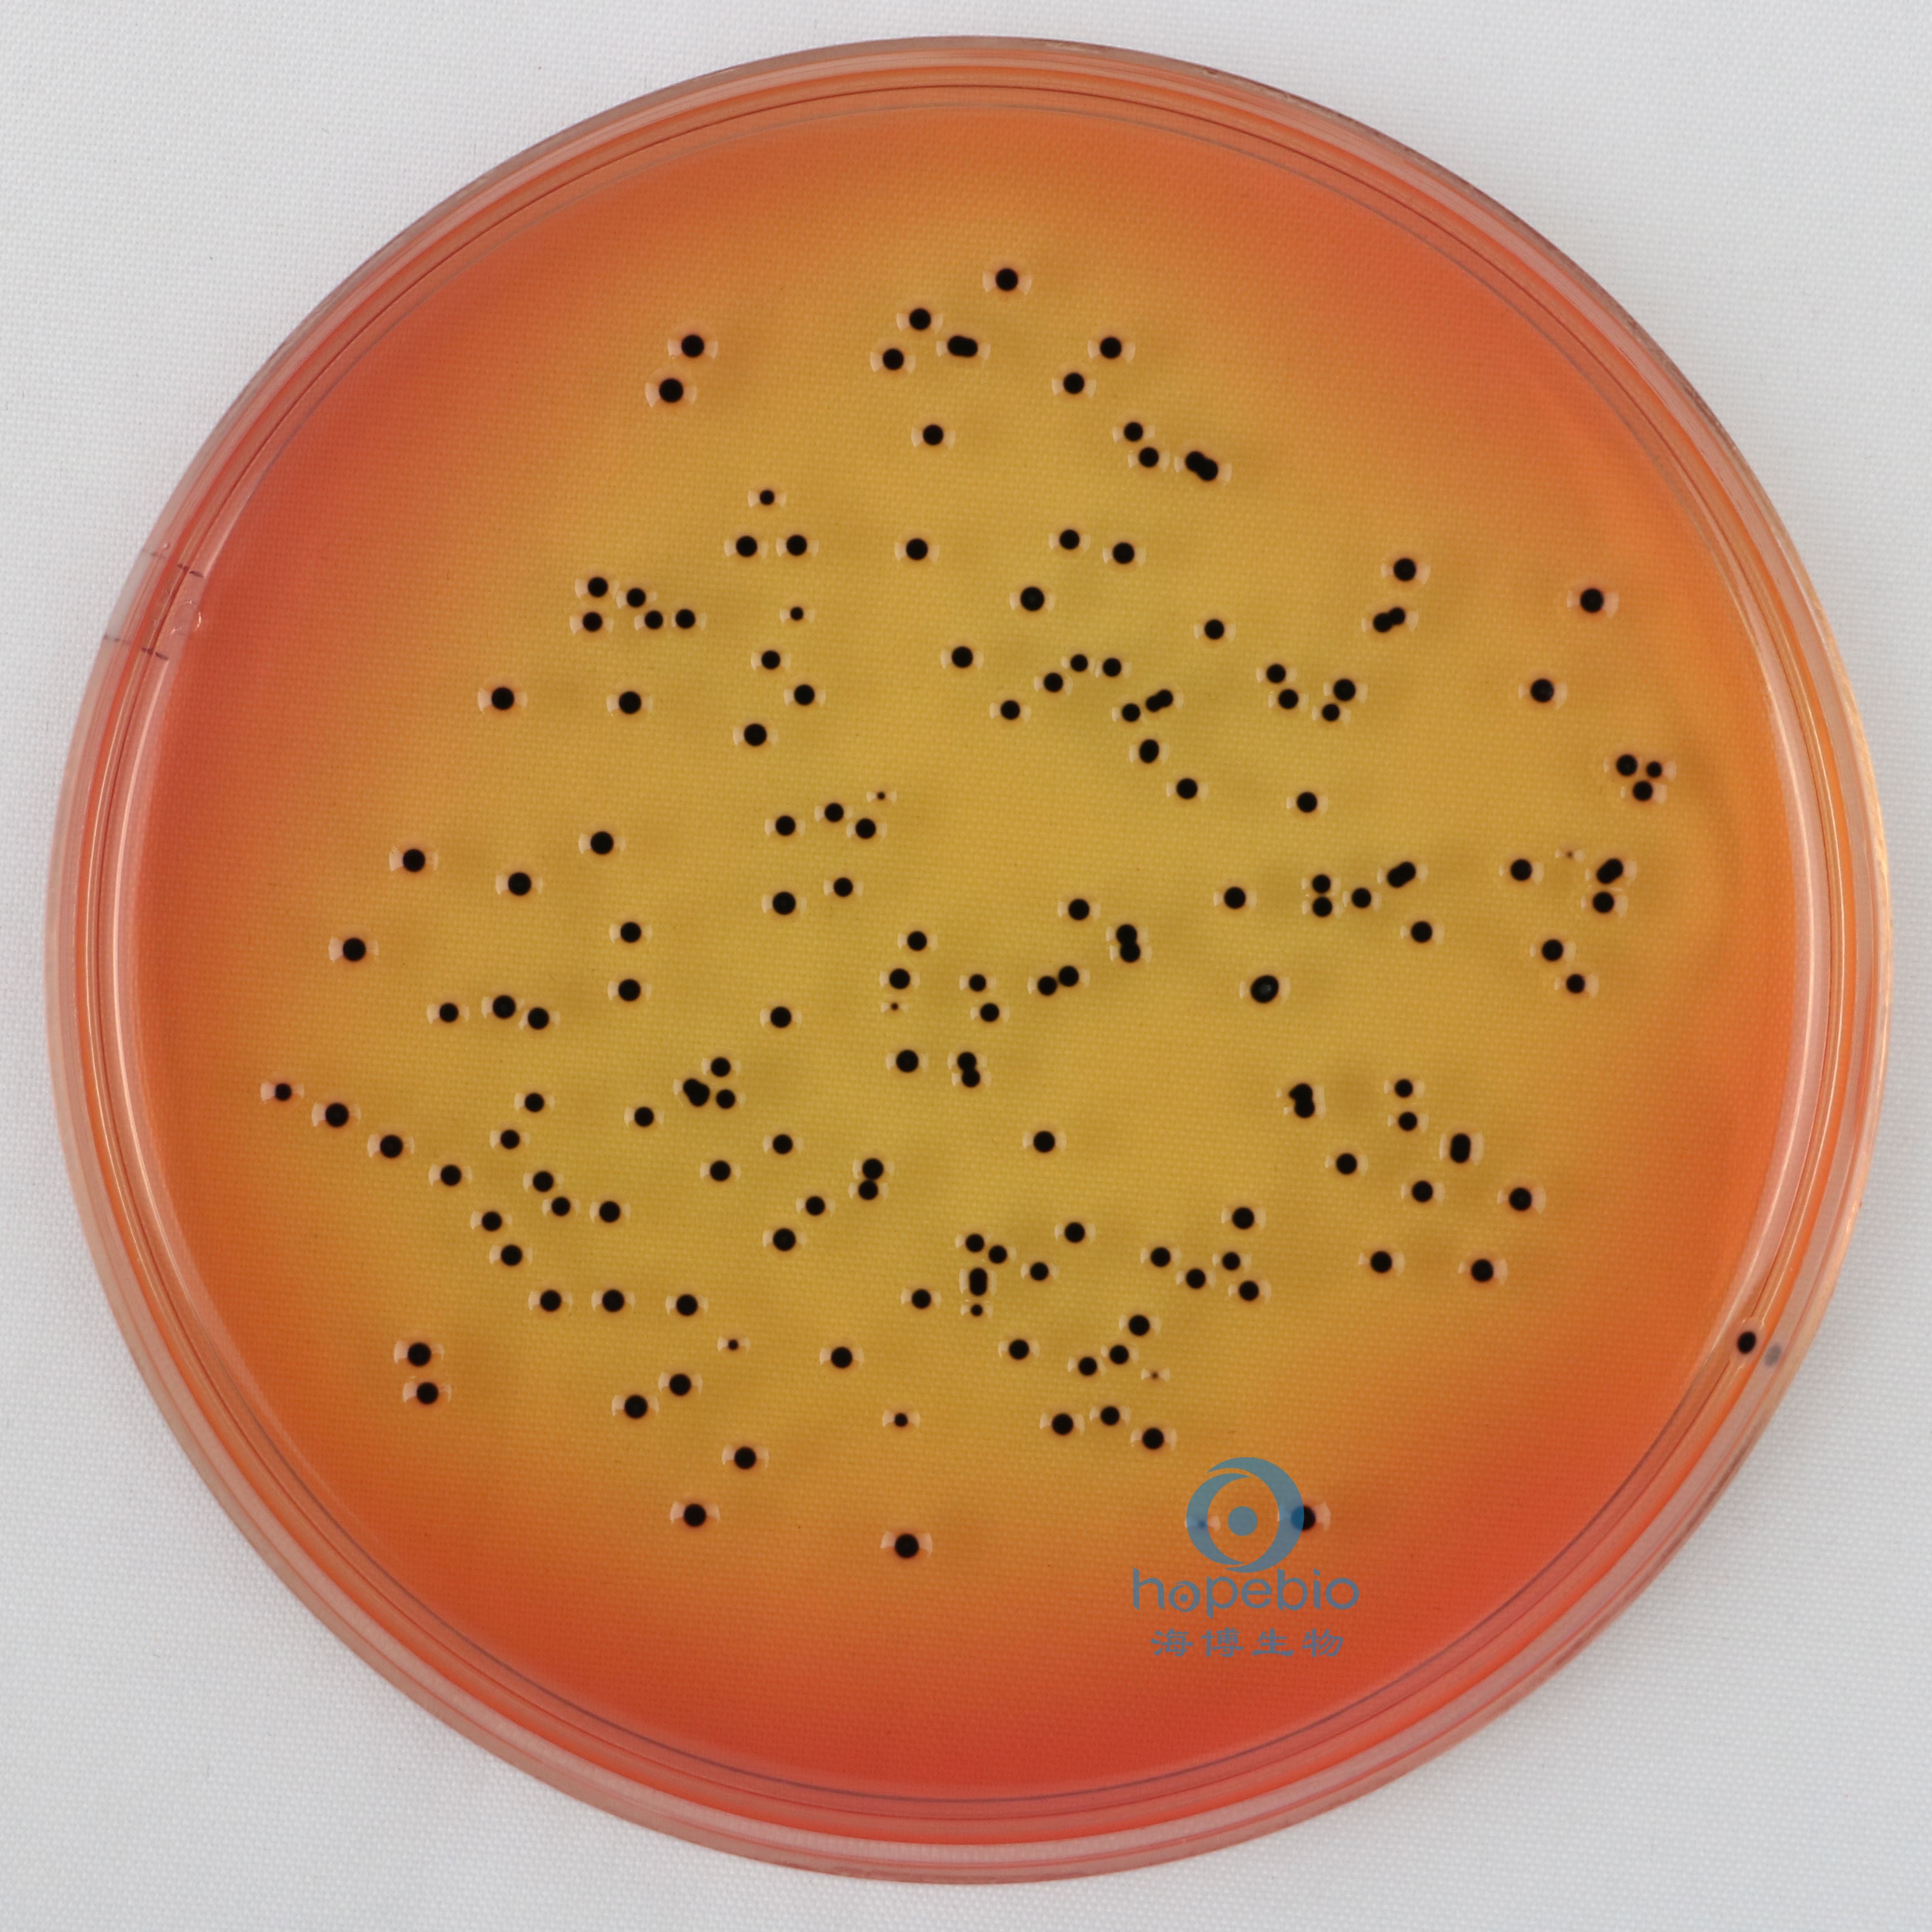
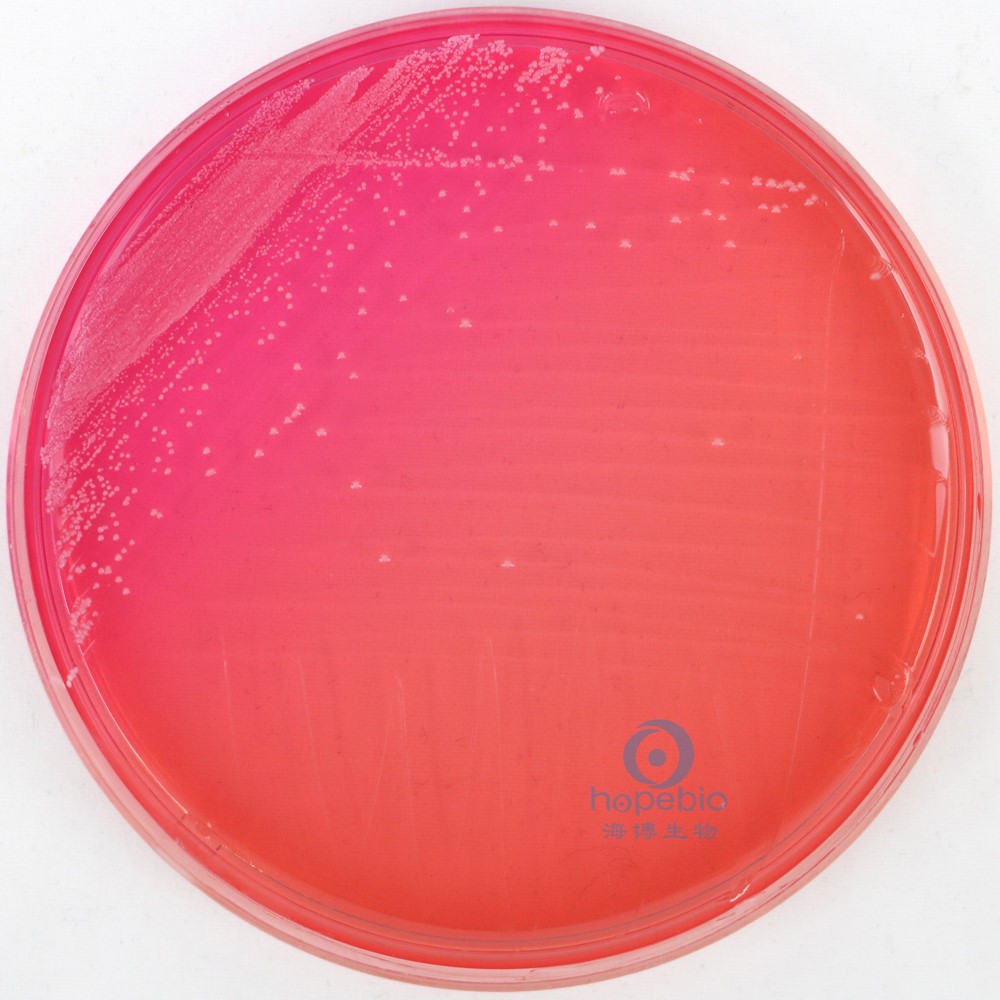
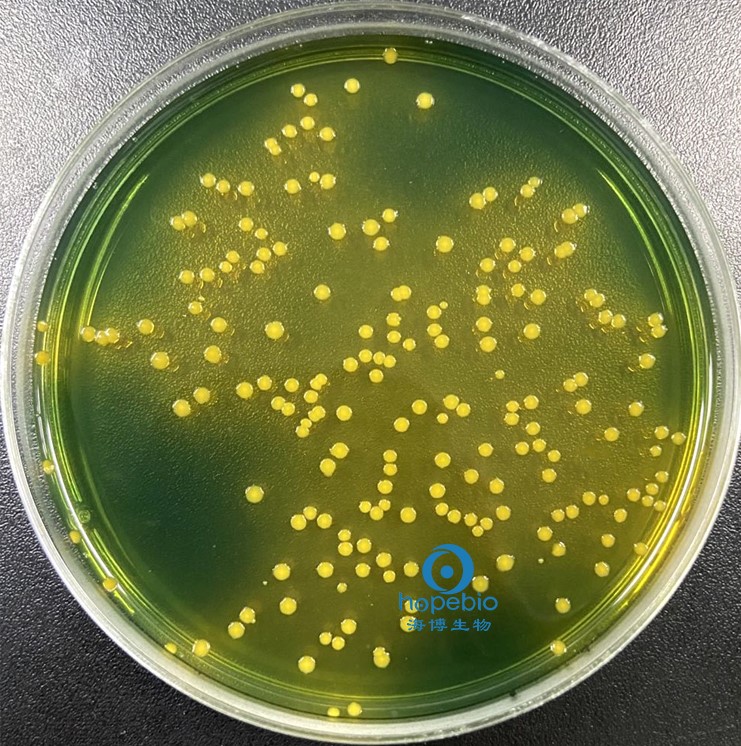

海博微信公众号
海博微信公众号
 海博天猫旗舰店
海博天猫旗舰店


 海博微信公众号
海博微信公众号
 海博天猫旗舰店
海博天猫旗舰店




在微生物学研究和临床检验中,培养基的核心功能不仅是为目标微生物提供营养,更需通过特定抑菌成分排除杂菌干扰,实现对目标菌的选择性分离与纯化。这些抑菌成分通过精准靶向微生物的生理结构或代谢途径,抑制非目标菌生长,同时不影响目标菌增殖,从而简化分离流程并提高鉴定效率。
一、抑菌成分的核心作用
选择性抑制是抑菌成分最主要的功能。通过针对特定类群微生物的生理弱点(如细胞壁结构、代谢途径、膜通透性),抑制或杀死非目标微生物(如杂菌、背景菌),从而促进目标微生物分离,从复杂样本(如土壤、粪便、临床标本)中分离出特定的、可能生长较慢或数量较少的微生物(如病原菌、特定益生菌);维持纯培养,在传代培养或长期保藏过程中,防止杂菌污染;在液体培养基中,抑制其他微生物生长,使目标微生物成为优势菌群;简化鉴定过程,如在鉴别培养基中,抑制背景菌生长,使目标菌的鉴别特征(如菌落颜色、溶血环)更易于观察。
在细胞培养或某些对无菌要求极高的微生物培养中,添加低浓度的抗生素(如青霉素-链霉素混合液)可预防细菌或真菌污染。
二、主要抑菌成分类别及机制
1、抗生素类
抗生素是由微生物(包括细菌、真菌、放线菌属)或高等动植物在生活过程中所产生的具有抗病原体或其他活性的一类次级代谢产物,能干扰其他生活细胞发育功能的化学物质。在培养基中,抗生素常被用于抑制特定类型的微生物,尤其是细菌。
抗生素的作用机制是干扰微生物的关键生命过程,包括抑制细胞壁合成、破坏细胞膜功能、抑制蛋白质合成及抑制核酸合成等。
其中如青霉素、氨苄青霉素、万古霉素等可以抑制细胞壁的合成,主要作用于革兰氏阳性菌的肽聚糖合成。青霉素是β-内酰胺类抗生素的代表,其抑菌机制是与细菌细胞膜上的青霉素结合蛋白结合,抑制肽聚糖合成过程中的转肽酶活性,阻断细胞壁交联反应,最终导致细菌因细胞壁缺陷而裂解。由于真菌(如酵母菌、霉菌)缺乏细胞壁结构,对青霉素不敏感,因此含青霉素的培养基可选择性培养真菌,广泛用于从污染细菌的样本中分离皮肤癣菌或念珠菌。
多粘菌素,特别是多粘菌素B可以破坏细胞膜功能,主要作用于革兰氏阴性菌的外膜;两性霉素B、制霉菌素与真菌细胞膜的麦角固醇结合。
链霉素、卡那霉素、庆大霉素等主要作用于细菌核糖体30S亚基,通过干扰tRNA与mRNA的结合,抑制蛋白质合成。在分离土壤中的固氮菌时,培养基中添加链霉素可有效抑制革兰氏阴性杂菌,而固氮菌因自身抗性得以生长;氯霉素、红霉素作为广谱抗生素,能与细菌核糖体50S亚基结合,阻止肽键形成,抑制蛋白质合成,在嗜血杆菌培养基(如巧克力琼脂)中,添加氯霉素可抑制多数革兰氏阳性菌和阴性菌,仅允许嗜血杆菌生长。
利福平抑制RNA合成、新生霉素抑制DNA旋转酶从而抑制核酸的合成。
2、化学试剂类
化学试剂类抑菌成分通过破坏微生物细胞膜、干扰代谢途径或抑制酶活性发挥作用,广泛应用于肠道致病菌等的分离。
胆盐及其衍生物(如脱氧胆酸钠、牛磺胆酸钠),其抑菌机制是通过降低细菌细胞膜表面张力,破坏脂质双层结构,导致细胞膜通透性增加,细胞内物质外漏。由于肠道致病菌(如沙门氏菌、志贺氏菌)对胆盐的耐受性显著高于肠道正常菌群(如大肠杆菌),因此含胆盐的SS琼脂成为肠道致病菌分离的经典培养基。SS琼脂中胆盐可抑制大多数非致病菌,同时配合柠檬酸钠和煌绿进一步增强选择性,最终使目标菌形成特征性菌落。
|
 |
|
肠炎沙门氏菌(黑色中心菌落) |
大肠埃希氏菌(桃红色菌落) |
叠氮化钠是一种强效代谢抑制剂,通过与细胞色素氧化酶中的铁离子结合,阻断电子传递链,抑制有氧呼吸。在肠球菌分离培养基中,叠氮化钠可抑制绝大多数需氧菌,而肠球菌因能通过发酵代谢获取能量且对其敏感性较低而得以存活。例如,叠氮钠血琼脂中,肠球菌可形成灰白色菌落并伴有β溶血,便于快速识别。
亚硫酸钠作为还原剂,可消耗培养基中的氧气,同时抑制需氧菌的氧化代谢。在庖肉培养基中,亚硫酸钠与肉渣共同作用,创造厌氧环境,抑制需氧菌生长,专门用于培养破伤风梭菌等厌氧菌。其抑菌机制不仅在于厌氧环境的构建,还能通过降低氧化还原电位,破坏需氧菌的能量代谢系统。
高浓度盐通过高渗透压使非耐盐菌细胞脱水(质壁分离),抑制其生长。在甘露醇盐琼脂中7.5%-10%的氯化钠可抑制大多数非葡萄球菌的细菌。葡萄球菌属通常能耐受此盐浓度。该培养基同时利用甘露醇发酵和酚红指示剂来鉴别金黄色葡萄球菌(发酵甘露醇产酸变黄)和表皮/腐生葡萄球菌(通常不发酵,菌落周围不变色或微红)。
 |
|
|
金黄色葡萄球菌(黄色菌落,菌落周围黄色) |
表皮葡萄球菌(红色菌落) |
其他如TCBS琼脂培养基通过胆盐和强碱性环境抑制非弧菌,用于分离霍乱弧菌(黄色菌落)和副溶血性弧菌(绿色菌落)。
|
 |
|
霍乱弧菌(黄色菌落) |
副溶血性弧菌(蓝绿色斗笠状菌落) |
3、染料类
染料类抑菌成分通过渗透进入微生物细胞,与核酸或蛋白质结合,干扰其功能,同时兼具指示作用,在鉴别培养基中应用广泛。
结晶紫是一种碱性染料,其阳离子可与细菌细胞膜上的阴离子结合,破坏膜结构,同时进入细胞内与DNA结合,抑制核酸复制。在麦康凯琼脂中,结晶紫可抑制革兰氏阳性菌生长,而革兰氏阴性菌因细胞膜结构差异(含脂多糖较多)对其敏感性较低。该培养基常用于分离肠道革兰氏阴性菌,如大肠杆菌可发酵乳糖产酸,使菌落呈现红色,而沙门氏菌等非发酵菌则为无色。
伊红与美蓝是酸性和碱性染料的组合,两者形成的复合物可抑制革兰氏阳性菌生长,其机制可能与破坏细胞膜通透性及干扰酶活性有关。EMB琼脂(伊红美蓝琼脂)中,伊红和美蓝的协同作用可有效抑制革兰氏阳性菌,同时通过乳糖发酵特性鉴别肠道菌,大肠杆菌发酵乳糖产酸,使菌落呈现紫黑色并带有金属光泽,而沙门氏菌等不发酵乳糖的细菌则形成无色或淡黄色菌落。
孔雀绿是一种三苯甲烷类染料,其抑菌机制是通过与微生物细胞内的酶(如脱氢酶)结合,抑制代谢过程,同时破坏细胞膜完整性。在沙堡弱培养基中添加孔雀绿可抑制细菌生长,专一培养真菌,尤其适用于皮肤癣菌的分离。

此外,孔雀绿在李斯特菌显色培养基中还可作为选择性抑制剂,抑制多数杂菌,同时与李斯特菌产生的磷脂酶反应形成特征性绿色菌落。

三、应用抑菌成分的注意事项
1、明确目标与选择,根据目标微生物的特性(如革兰氏阳性菌/革兰氏阴性菌、耐盐性、特殊代谢能力)和需要抑制的杂菌类型,科学选择合适的抑菌剂及其浓度。
2、浓度精准控制,浓度过低无法有效抑制杂菌;浓度过高可能抑制甚至杀死目标微生物,或诱导耐药性。务必参照标准配方或文献。
3、稳定性与兼容性,某些抑菌剂(如某些抗生素、叠氮化钠)对热、光或pH敏感,需注意灭菌方式(过滤除菌或高压灭菌)和储存条件。确保抑菌剂与其他培养基成分无拮抗。
4、耐药性问题,长期使用单一抗生素可能导致耐药菌株出现。在长期培养或富集过程中需注意。
5、安全第一,许多抑菌剂(如叠氮化钠、结晶紫、抗生素)具有毒性或潜在致癌性。操作时务必佩戴手套等防护装备,并按规定处理废弃物。
6、可能影响目标微生物特性,添加抑菌剂可能会微妙地改变目标微生物的代谢、形态或生长速度,在解释实验结果时需考虑此因素。
四、相关产品
部分含有抑菌成分的培养基:
|
产品货号 |
产品名称 |
用途 |
|
HB4089 |
用于沙门氏菌,志贺氏菌的选择性分离培养(GB标准) |
|
|
HB4128 |
用于金黄色葡萄球菌的选择性分离培养。 |
|
|
HB4130 |
用于致病性弧菌的选择性分离。 |
|
|
HB0107 |
弱选择性培养基,用于分离肠道致病菌,特别是大肠杆菌。 |
|
|
HB9306 |
用于真菌检测 |
|
|
HB7008 |
用于李斯特氏菌的显色培养,单增李斯特氏菌显蓝色,外围有一不透明环 |
注:本文属海博生物原创,未经允许不得转载。
| 相关文章: | ||



